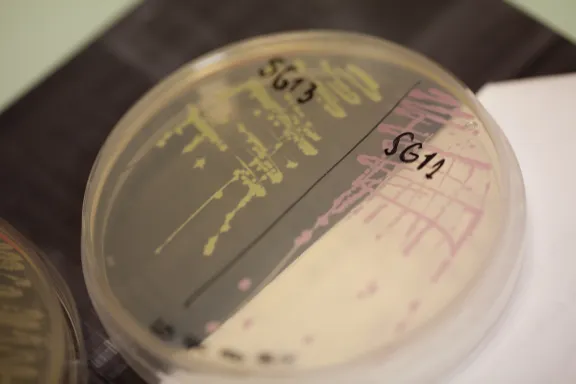

Marcelo Nollmann Dévoiler le pourquoi de l'architecture des chromosomes, une cellule à la fois
Marcelo Nollmann, directeur de recherche au CNRS
- 2017 • Prix Bettencourt Coups d’élan pour la recherche française

Le Prix Bettencourt Coups d’élan pour la recherche française 2016 récompense Marcelo Nollmann, Directeur de recherche au CNRS, pour ses recherches sur la chromatine, protéine qui participe de la construction du chromosome.
L'architecture des chromosomes
L'équipe de Marcelo Nollmann utilise une combinaison unique d'outils de microscopie pour révéler l'impact de l'architecture tridimensionnelle des chromosomes sur leurs fonctions et celles des cellules. La manière dont l'ADN est organisé dans le noyau d'une cellule ne doit rien au hasard. On le trouve généralement sous forme de chromatine, associé aux histones, des protéines qui guident son repliement et régulent son expression. L'équipe de Marcelo Nollmann explore la forme de la chromatine à différentes échelles, depuis le minuscule nucléosome, large d'une centaine de paires de bases, jusqu'au chromosome complet, en passant par les structures intermédiaires. Ces structures appelées domaines topologiques, semblent particulièrement importants pour la régulation de la transcription pendant les processus de développement et différenciation.
Le soutien de la Fondation
Le projet soutenu par la Fondation vise à découvrir des molécules et mécanismes impliqués dans l'établissement et la maintenance de l’architecture tridimensionnelle de la chromatine. L'interaction entre cette architecture et d'autres fonctions du noyau telles que la transcription sera également examinée. L'équipe va pour cela s'appuyer sur un large spectre de microscopies avancées à haute performance, installées dans des nouveaux locaux avec l'aide du prix Coup d'élan.
Marcelo Nollmann en quelques mots
Marcelo Nollmann obtient un master en physique en Argentine, son pays natal, puis un autre en génétique moléculaire en Écosse. Il associe ensuite ces deux compétences lors d'un doctorat en biophysique moléculaire qui s'intéresse aux relations structure-fonction de la résolvase Tn3, une enzyme de recombinaison génétique. Lorsqu'il arrive à Berkeley, il développe des approches de manipulation de molécules individuelles, telles que les pinces magnétiques et optiques, pour découvrir les mécanismes de ségrégation d’ADN pendant la division cellulaire bactérienne et pour décortiquer les fonctions des topoisomérases, protéines impliquées dans le maintien de l'état topologique de l’ADN.
Depuis son installation à Montpellier, son équipe a développé des techniques novatrices de microscopie avancée pour la détection des molécules individuelles dans des cellules vivantes. Ces technologies de pointe ont permis un avancement important dans notre compréhension des diverses processus fondamentaux, comme l’organisation des génomes, la ségrégation des chromosomes pendant la division cellulaire prokaryote, ou la motilité bactérienne.

Prix Bettencourt Coups d’élan pour la recherche française
Le Prix Coups d’élan pour la recherche française a été créé par la Fondation en 2000, il a récompensé 78 laboratoires français et plus de 900 chercheurs ont bénéficié de ce prix. Jusqu'en 2021, ce prix était attribué chaque année à quatre équipes de recherche, relevant de l’Inserm et de l’Institut des sciences biologiques du CNRS. La dotation du prix était de 250 000 euros par laboratoire lauréat.
Tous les lauréats du prix




